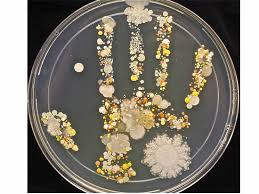

Pokiaľ sa pozrieme pomocou špeciálnych prístrojov na svoje ruky, naskytne sa nám hrôzostrašný pohľad. Nedávno vedkyňa Tasha Sturm z USA poprosila svojho syna, ktorý sa vrátil z prechádzky, priložiť dlaň do misky z roztokom, ktorý tvorí živnú pôdu pre mikroorganizmy. Po niekoľkých dňoch sa miska zaplnila rozrastajúcimi baktériami, kvasinkami a hubami, ktoré vytvorili tvar ruky chlapca.
Pokiaľ sa pozrieme pomocou špeciálnych prístrojov na svoje ruky, naskytne sa nám hrôzostrašný pohľad. Nedávno vedkyňa Tasha Sturm z USA poprosila svojho syna, ktorý sa vrátil z prechádzky, priložiť dlaň do misky z roztokom, ktorý tvorí živnú pôdu pre mikroorganizmy. Po niekoľkých dňoch sa miska zaplnila rozrastajúcimi baktériami, kvasinkami a hubami, ktoré vytvorili tvar ruky chlapca.
„Predpokladá sa, že v ľudskom organizme v tráviacom trakte a na pokožke sa nachádza od 4 do 8 kg priateľských baktérií,“ vysvetlila profesorka katedry mikrobiológie Biologickej fakulty Moskovskej štátnej univerzity Irina Kotova.
„Tieto mikroorganizmy sú rozložené rovnomerne na povrchu pokožky a chránia nás od iných patogénnych organizmov zo životného prostredia okolo nás. Priateľské baktérie produkujú kyseliny a zásady, ktoré neumožňujú rozvíjať sa cudzím baktériám. Preto likvidovať a odstraňovať túto vrstvu priateľských baktérií je nebezpečné pre zdravie. Je to možné urobiť pomocou obyčajného antibakteriálneho mydla.
Umývať ruky antibakteriálnymi prostriedkami by sme si mali maximálne 1 krát týždenne, alebo vôbec. Inak bude pokožka sterilná a škodlivé baktérie ako streptokoky, stafylokoky, tuberkulózne baktérie a mnohé iné sa ľahko na nej usadia.“





